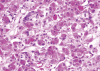

Primary acinic cell carcinoma of the breast: a case report with an immunohistochemical and ultrastructural studies
- PMID: 21847414
- PMCID: PMC3148534
- DOI: 10.4048/jbc.2011.14.2.160
Primary acinic cell carcinoma of the breast: a case report with an immunohistochemical and ultrastructural studies
Abstract
Acinic cell carcinoma (ACC) of the breast is extremely rare and is characterized by widespread acinar cell-like differentiation. We report of a 39-year-old woman presented with a palpable breast mass with significant morphological, immunohistochemical and ultrastructural findings. Histologically, ACC showed a diffuse glandular infiltrative pattern, with small acinar or glandular structures mixed with solid nests. Neoplastic cells were monotonous proliferation of cells with a granular or clear cytoplasm, resembling acinar cells of the salivary glands or Paneth cells. Both glandular and solid tumor cell populations were strongly positive for lysozyme and α-1-antitrypsin.
Keywords: Acinic cell carcinoma; Breast neoplasms; Electron microscopy; Immunohistochemistry.
Figures

References
-
- Roncaroli F, Lamovec J, Zidar A, Eusebi V. Acinic cell-like carcinoma of the breast. Virchows Arch. 1996;429:69–74. - PubMed
-
- Matoso A, Easley SE, Gnepp DR, Mangray S. Salivary gland acinar-like differentiation of the breast. Histopathology. 2009;54:262–263. - PubMed
-
- Damiani S, Pasquinelli G, Lamovec J, Peterse JL, Eusebi V. Acinic cell carcinoma of the breast: an immunohistochemical and ultrastructural study. Virchows Arch. 2000;437:74–81. - PubMed
-
- Tanahashi C, Yabuki S, Akamine N, Yatabe Y, Ichihara S. Pure acinic cell carcinoma of the breast in an 80-year-old Japanese woman. Pathol Int. 2007;57:43–46. - PubMed
-
- Hirokawa M, Sugihara K, Sai T, Monobe Y, Kudo H, Sano N, et al. Secretory carcinoma of the breast: a tumour analogous to salivary gland acinic cell carcinoma? Histopathology. 2002;40:223–229. - PubMed
Publication types
LinkOut - more resources
Full Text Sources

